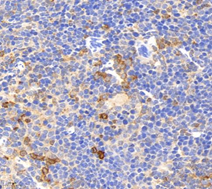

Anti-NLRP3 Rabbit pAb
- 100 μL
Product Information
Description | NLRP3 rabbit polyclonal antibody |
Protein full name | NACHT, LRR and PYD domains-containing protein 3 |
Synonyms | NLRP3, AGTAVPRL, AII, AVP, C1orf7, CIAS1, CLR1.1, FCAS, FCAS1, FCU, MWS, NALP3, PYPAF1, NLR family, pyrin domain containing 3, NLR family pyrin domain containing 3 |
Immunogen | KLH conjugated Synthetic peptide corresponding to Mouse NLRP3 |
Isotype | IgG |
Purity | Affinity purification |
Subcellular location | Cytoplasm, Secreted, Nucleus |
Uniprot ID | Q96P20, Q8R4B8 |
Applications
Applications | Species | Dilution | Positive Sample |
IHC/IF | Human, Mouse, Rat | 1:600-1:1200 | bladder cancer, spleen, tonsil |
Background
NALP3 is a component of the innate immune system that functions as a pathogen recognition receptor (PRR) that recognizes pathogen-associated molecular patterns (PAMPs). NALP3 belongs to the NOD-like receptor (NLR) subfamily of PRRs and NALP3 together with the adaptor ASC protein PYCARD forms a caspase-1 activating complex known as the NALP3 inflammasome. NALP3 in the absence of activating signal is kept in an inactive state complexed with HSP90 and SGT1 in the cytoplasm.
Images
![]() | Immunohistochemistry of paraffin embedded mouse spleen using NLRP3 (GB11300) at dilution of 1:600 (400x lens) |
| Immunofluorescence of paraffin embedded human bladder cancer using NLRP3 (GB11300) at dilution of 1:600 (400x lens) |
| Immunofluorescence of paraffin embedded human tonsil using NLRP3 (GB11300) at dilution of 1:600 (400x lens) |
Storage
| Storage | Store at -20 ℃ for one year. Avoid repeated freeze/ thaw cycles. |
| Storage Buffer | PBS with 0.02% sodium azide, 100 μg/ml BSA and 50% glycerol. |
NOTE:
1.This product is intended for research only.
2.This product is recommended to dilute with the Primary Antibody Dilution Buffer (G2025).
Publications:
Title | Journal | Pubmed ID | Application | |
1 | Roseburia intestinalis-derived flagellin ameliorates colitis by targeting miR-223-3p-mediated activation of NLRP3 inflammasome and pyroptosis. | Molecular Medicine Reports | 32700754 | IF |
2 | Interleukin-22 Attenuated Renal Tubular Injury in Aristolochic Acid Nephropathy via Suppressing Activation of NLRP3 Inflammasome. | Frontiers in Immunology | 31616439 | IHC |
| 货号 | 名称 | 规格 | 价格 | 操作 |
|---|
| 货号 | 名称 | 规格 | 价格 | 操作 |
|---|